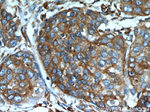
GRP94 Antibody in Immunohistochemistry (Paraffin) (IHC (P))

Search
Proteintech
GRP94 Polyclonal Antibody
{{$productOrderCtrl.translations['antibody.pdp.commerceCard.promotion.promotions']}}
{{$productOrderCtrl.translations['antibody.pdp.commerceCard.promotion.viewpromo']}}
{{$productOrderCtrl.translations['antibody.pdp.commerceCard.promotion.promocode']}}: {{promo.promoCode}} {{promo.promoTitle}} {{promo.promoDescription}}. {{$productOrderCtrl.translations['antibody.pdp.commerceCard.promotion.learnmore']}}
产品信息
14700-1-AP
种属反应
已发表种属
宿主/亚型
分类
类型
抗原
偶联物
形式
浓度
规格
纯化类型
保存液
内含物
保存条件
运输条件
产品详细信息
This antibody was generated against the C-terminal region of full-length HSP90b1.
Immunogen sequence: KLLKVIRKK LVRKTLDMIK KIADDKYNDT FWKEFGTNIK LGVIEDHSNR TRLAKLLRFQ SSHHPTDITS LDQYVERMKE KQDKIYFMAG SSRKEAESSP FVERLLKKGY EVIYLTEPVD EYCIQALPEF DGKRFQNVAK EGVKFDESEK TKESREAVEK EFEPLLNWMK DKALKDKIEK AVVSQRLTES PCALVASQYG WSGNMERIMK AQAYQTGKDI STNYYASQKK TFEINPRHPL IRDMLRRIKE DEDDKTVLDL AVVLFETATL RSGYLLPDTK AYGDRIERML RLSLNIDPDA KVEEEPEEEP EETAEDTTED TEQDEDEEMD VGTDEEEETA KESTAEKDEL (455-803 aa encoded by BC066656)
靶标信息
GRP94 is a 803 amino acid protein belonging to the heat shock protein 90 family. It acts as a molecular chaperone that functions in the processing and transport of secreted proteins. GRP94 and its N-terminal fragment stimulates CTL expansion and maturation of human monocyte-derived dendritic cells (MDDC). It plays a central role in innate as well as acquired immunity, maturation and chemotaxis of dendritic cells, Ab production, cross-priming, as a potential marker in breast cancer and is a peptide acceptor in endoplasmic reticulum and an accessory to peptide loading of MHC class I molecules. Expression of GRP94 suppressed A23187-induced apoptosis and stabilized calcium homeostasis. GRP94 is expressed in melanoma or liver metastases of colon carcinoma cells, human gastric carcinoma BGC-823 cells.
仅用于科研。不用于诊断过程。未经明确授权不得转售。
生物信息学
蛋白别名: 94 kDa glucose-regulated protein; 94 kDa glucose-regulated protein {ECO:0000250|UniProtKB:P08113}; Endoplasmic reticulum resident protein 99; Endoplasmin; endoplasmin {ECO:0000250|UniProtKB:P08113}; endothelial cell (HBMEC) glycoprotein; epididymis luminal protein 35; epididymis secretory sperm binding protein Li 125m; ERp99; gp96 homolog; GRP-94; Heat shock protein 90 kDa beta member 1; heat shock protein 90 kDa beta member 1 {ECO:0000250|UniProtKB:P08113}; heat shock protein 90kDa beta (Grp94), member 1; heat shock protein 90kDa beta family member 1; Heat shock protein family C member 4; hsp90b1 {ECO:0000250|UniProtKB:P08113}; Polymorphic tumor rejection antigen 1; stress-inducible tumor rejection antigen gp96; transforming growth factor alpha regulated gene 2; tumor rejection antigen (gp96) 1; Tumor rejection antigen 1; Tumor rejection antigen gp96; unnamed protein product
基因别名: ECGP; endoplasmin; ERp99; GP96; GRP94; HEL-S-125m; HEL35; HSP90B1; HSPC4; TA-3; Targ2; Tra-1; TRA1
UniProt ID: (Human) P14625, (Mouse) P08113, (Rat) Q66HD0
Entrez Gene ID: (Human) 7184, (Mouse) 22027, (Rat) 362862